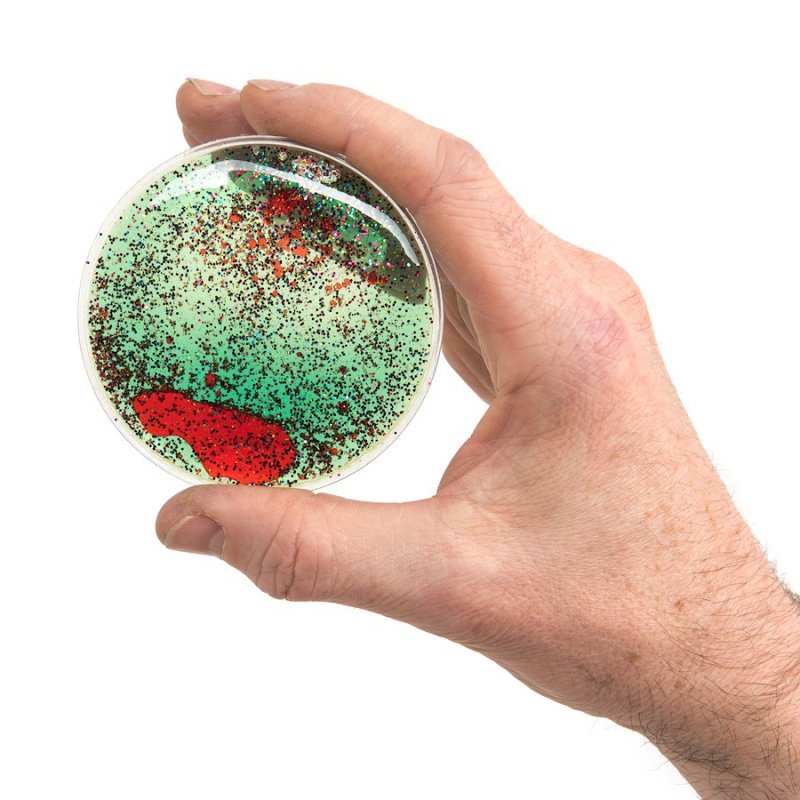

1.- Som ràpids!
Les comandes que ens arriben abans de la 13h surten el mateix dia (si és laborable) amb missatgeria de 24/48h per península*.
Si la comanda arriba després de la 13h, surt el proper dia laborable també amb missatgeria 24/48h.
*Les comandes pagades amb transferència bancaria surten quan ens arriba el pagament. El temps d´entrega a Balears és de 72/96h.
2.- Quin cost te l'enviament?
Península: 5,95 € o GRATUÏT en comandes superiors a 80 €
Balears: 12€ per a comandes de menys de 120€ i 25€ per a comandes superiors a 120€.
No fem enviaments (de moment) a les Illes Canaries, Ceuta o Melilla. :(
3.- Tenim cura de l´enviament
Fem personalment el seguiment de tots els enviament perquè arribin a temps. I ens pots trucar en qualsevol moment per saber com es troba la teva comanda. Som aquí per ajudar-te!
4.- Les devolucions són gratuïtes!
I si no t´agrada el que reps, ho tornes i tan amics!
Sense donar explicacions ni cap cost extra.
1.- Som ràpids!
Les comandes que ens arriben abans de la 13h surten el mateix dia (si és laborable) amb missatgeria de 24/48h per península*.
Si la comanda arriba després de la 13h, surt el proper dia laborable també amb missatgeria 24/48h.
*Les comandes pagades amb transferència bancaria surten quan ens arriba el pagament. El temps d´entrega a Balears és de 72/96h.
2.- Quin cost te l'enviament?
Península: 5,95 € o GRATUÏT en comandes superiors a 80 €
Balears: 12€ per a comandes de menys de 120€ i 25€ per a comandes superiors a 120€.
No fem enviaments (de moment) a les Illes Canaries, Ceuta o Melilla. :(




Has d'estar registrat

Es prem el líquid amb els dits i es poden anar veient els diferents patrons que es van formant.A més es poden col·locar un sobre l'altre a la taula de llum descobrint la combinació colors.

Criden l'atenció dels més petits, els manipulen, rebreguen, dobleguen i queden fascinats per la seva textura. Són a més molt resistents i el gel que contenen no és tòxic.